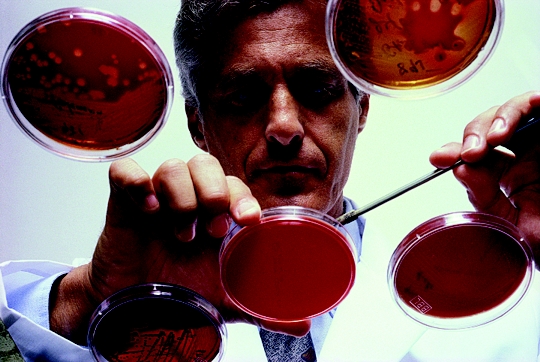

Regreso al origen
No todo lo que puede ser contado cuenta,
y no todo lo que cuenta puede ser contado.
Fundamentalmente a lo largo de la segunda mitad del siglo XX, la ciencia en el mundo se transformó y dejó de ser la actividad que busca satisfacer la curiosidad humana para convertirse en una actividad supervisada y cuantificada, a tal grado que para muchos científicos ahora la prioridad de su trabajo es satisfacer parámetros de productividad, como número de citas y publicaciones, y no necesariamente satisfacer la curiosidad humana, la cual pasa a segundo término. Si éste es realmente el caso, se puede afirmar que la aplicación de estos parámetros afecta negativamente a la actividad científica.
Hasta el inicio del siglo pasado, la comunidad científica era pequeña. Se publicaban los resultados de la investigación en unas cuantas revistas, las cuales en conjunto contenían un resumen del conocimiento científico acumulado hasta esa época. De modo un tanto romántico, los científicos trabajaban por el placer de satisfacer tanto la curiosidad humana como su ego.
En la actualidad la comunidad científica es numerosa, y aunque sin duda el ego sigue siendo un móvil importante, probablemente la satisfacción de la curiosidad científica está pasando a un segundo plano. Esto último debido a que ahora los científicos son presionados para trabajar en publicar artículos y realizar otras actividades que deben de ser "objetivamente cuantificadas".
Para evaluar el trabajo de los científicos se han inventado parámetros que pretenden dar respuestas sencillas a problemas complejos, como es sin duda pretender medir la productividad, calidad e impacto del Trabajo de un científico. Se insiste en referirse al "factor de impacto" de las revistas científicas, a pesar de que éste sólo se refiere a un promedio de citas en revistas publicadas por el Institute for Scientific Information (ISI) durante los últimos dos años. Podemos preguntar, ¿por qué sólo las revistas del ISI y por qué sólo dos años? Este factor no dice nada sobre cuántas citas recibe un artículo particular, del mismo modo que el número promedio de miembros de una familia, dado por el Instituto Nacional de Estadística, Geografía e Informática (INEGI) en nuestro país no dice nada sobre la familia particular del lector de esta hoja.
El factor de impacto fue creado a finales de los años cincuenta como una forma de medir el valor de una revista calculando el número promedio de citas por artículo durante un periodo específico. Sin embargo, en opinión de muchos científicos, el factor de impacto ha adquirido tanto poder que ahora es este factor lo que controla la actividad científica, y ya no la curiosidad o el interés científico. Este factor es hoy determinante en la vida científica, por ejemplo al contratar, evaluar y al otorgar becas a científicos. En un artículo reciente de Monastersky, Richard (2005), "The number that's devouring science", The chronicle of higher education, 14 de octubre (http://chronicle.com/colloquy/2005/ 10/ impact/) se argumenta que la gente usa inadecuadamente el factor de impacto debido a que no hay principios explícitos que controlen su interpretación. Es decir, el factor de impacto se está usando para medir cosas para las cuales no fue diseñado (es decir, artículos y autores), y también se está usando para comparar cosas que no son comparables (las revistas mismas).Existe una extensa literatura sobre los problemas y abusos del factor de impacto: Amin, M. y M. Mabe (2000), "Impact factor, use and abuse", Elsevier Science (http://www.elsevier.com/framework_editors/pdfs/ Perspectives1.pdf). El problema fundamental radica en la obsesión de medir todo "objetivamente", y no es sorprendente que con frecuencia los desesperados evaluadores hagan uso de un parámetro pobremente comprendido, pero fácilmente calculable.
Como se ha mencionado, el factor de impacto se calcula a partir de datos proporcionados por el ISI, que se basa en la información de varios miles de revistas científicas. Por ejemplo, el factor de impacto para una revista X en el 2005 es el cociente A/B, donde A es el número de citas a artículos publicados en la revista X durante 2003 y 2004, y B es el número de artículos publicados por X durante 2003 y 2004. Por tanto, un factor de impacto de 1.5 para la revista X en el 2005 significa que, en promedio, los artículos publicados durante 2003 y 2004 fueron citados 1.5 veces dentro de las revistas registradas por el ISI en 2005.
Ejemplos interesantes son el New England Journal of Medicine, con un factor de impacto de 34.8, y el Journal of Superconductivity, con factor de impacto de 0.793. ¿Debemos concluir que la primera revista es 43.88 veces mejor (34.8/0.793 = 43.88) que la segunda? O más aún: ¿debemos concluir que un investigador que publica en la primera revista es 43.88 veces mejor que el investigador que publica en la segunda revista? Todavía más desconcertante: ¿debemos concluir que la medicina es 43.88 veces más importante que la superconductividad?
Por otra parte y como ejemplo: si a un investigador se le exige en una universidad o instituto de investigación publicar un artículo al año en revistas con factor de impacto 1.0, entonces si dicho investigador en un año publica un artículo en una revista con factor de impacto 43.8, ¿podría pasarse los 42.8 años restantes sin publicar nada?
Otro punto importante sobre este ejemplo, y dada la distribución de incentivos en muchas instituciones: ¿sería correcto pagarle 43.88 veces más a un investigador que a otro?
Ya que el factor de impacto proporciona, en principio, información sobre las revistas, y no sobre los investigadores, algunas personas pretenden complementar la información particular de un investigador indicando el Número de citas que éste tiene. Pero, ¿nos dice esto realmente algo sobre el investigador? Uno de los artículos más citados en física de plasmas contiene una receta numérica para interpretar interferogramas de plasmas. Nadie en su sano juicio podría afirmar que ese artículo contiene ciencia más importante que muchos otros artículos más relevantes en ésta y muchas otras áreas.
Por otra parte, ;que investigador no se ha topado, al revisar una tesis de maestría o doctorado, con que el estudiante cita un artículo que en realidad nunca ha leído, pero que incluye en las referencias de su tesis y de sus artículos por la razón de que "todo mundo lo cita"? El autor del artículo X está incrementando alegremente el "contador de citas" de su currículum sin importar el valor real de su artículo (¡como taxista!).
Hay, al menos, las siguientes objeciones para no considerar el número de citas como un parámetro objetivo: el valor de una cita depende de quién hace la cita; no es igual ser citado por un premio Nobel que por un novato estudiante que probablemente no entiende ni lo que cita. Por otra parte, muchos artículos pueden recibir citas involuntarias o irreflexivas, que no deben tener el mismo valor. Además, podríamos también preguntar: ¿que vale más, un artículo que es citado 10 veces en su primer año de publicación u otro que es citado 100 veces en los primeros cincuenta años?

Aparte de esto, se debe de reconocer que los artículos juegan diferentes papeles en la actividad científica: hay artículos que generan nuevas ideas en otros investigadores; hay artículos que son excelentes lecturas básicas sobre un tema, pero que no generan en sus lectores nuevas ideas, y hay también artículos que pueden no ser tan buenos, pero que contienen esa pequeña parte que es la clave que otro investigador necesita para terminar una nueva investigación.
¿Cual de los tres artículos anteriores es más importante? ¿Es un artículo de revisión que es leído superficialmente por muchos lectores más o menos importante que un artículo que ayuda a generar una nueva y promisoria idea? Igualar el número de citas de un artículo con su valor intrínseco es incorrecto, pues no se toman en cuenta las respuestas a las preguntas anteriores.
Por otra parte, ¿que se va a hacer con las nuevas publicaciones electrónicas? Por ejemplo, la revista Philica (http://philica.com) publica automáticamente todo artículo que sea enviado. Estos artículos son sujetos a permanente revisión por árbitros anónimos y por visitantes de dicha página web. ¿Van a sumar estos artículos puntos en la evaluación de los científicos o no? No es aconsejable una respuesta precipitada: hay que recordar que una de las medallas Fields (el equivalente del Premio Nobel en la matemática) del año 2006 fue otorgada al matemático Grigory Perelman (quien por cierto declinó recibir el premio), el cual publicó mucho de su trabajo en la red (ver: http://arxiv.org), pues no era bien visto por los árbitros de algunas famosas revistas. ¿Cómo podrán evitar los miembros de los comités de evaluación que investigadores publiquen cientos de artículos utilizando esas nuevas tecnologías?
Tenemos además la siguiente pregunta: un artículo publicado en la red y que es permanentemente arbitrado, ¿vale menos o más que un artículo publicado en una revista convencional con sólo uno o dos arbitrajes? Las citas a los artículos publicados usando estas nuevas tecnologías, ¿valen más, menos o igual que las citas de artículos en revistas convencionales?
¿A qué conclusión nos llevan todas estas preguntas, y las contradicciones que generan? Probablemente a la de que todas, absolutamente todas las formas de evaluación son falibles y pueden producir aberraciones y resultados absurdos.
¿Está perdida para siempre la época en que la ciencia se hacía por satisfacer la curiosidad humana? No lo sé. Lo que sí sé es que el sistema actual estimula a los investigadores a trabajar en la producción de artículos científicos aunque éstos sean redundantes, inútiles y ociosos, y no a involucrarse en problemas de mayor imaginación y exigencia creativa, pero en los que el riesgo de no poder publicar tantos artículos es mayor.
Vicente Aboites realizó estudios de física en la Universidad Autónoma Metropolitana, así como de filosofía en la Universidad de Londres. Realizó su trabajo doctoral en el Laboratorio Rutherford, en Oxford, y presentó su tesis en la Universidad de Essex, Inglaterra. En 1986 fundó el Laboratorio de Láseres del Centro de Investigaciones en Óptica (CIO), donde es profesor e investigador. Ha publicado numerosos libros y artículos técnicos, además de cientos de artículos periodísticos, y ha dirigido tesis de doctorado, maestría y licenciatura. Es miembro de Instituto de Física (Gran Bretaña), de la Sociedad Británica para la Filosofía de la Ciencia, de la Sociedad Internacionel de Filosofía y de la Academia Mexicana de Ciencias. Esta dirección de correo electrónico está siendo protegida contra los robots de spam. Necesita tener JavaScript habilitado para poder verlo.
